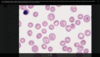
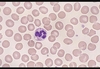
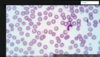
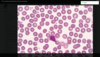
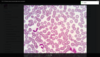
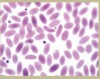

What is hematopoiesis?
The production of blood cells and platelets
What are the components of whole blood?
Fluids and cells
What is the fluid portion of blood called?
Plasma
List the types of cells found in whole blood.
- RBCs
- WBCs
- Thrombocytes (platelets)
What are agranulocytes?
White blood cells with no granules present
Name the types of agranulocytes.
- Lymphocytes
- Monocytes
What are granulocytes?
White blood cells with granules
List the types of granulocytes.
- Neutrophils
- Eosinophils
- Basophils
What is the lifespan of blood cells? Delete
Constantly produced and have a finite life span
Where does hematopoiesis occur in adults?
Primarily in red bone marrow
What is erythropoiesis?
Production of erythrocytes (red blood cells)
What is leukopoiesis?
Production of leukocytes (white blood cells)
What is thrombopoiesis?
Production of thrombocytes (platelets)
What is the role of pluripotent hematopoietic stem cells (HSC)?
All blood cells arise from this cell
What cytokine is responsible for the production of RBCs?
Erythropoietin (EPO)
Where is erythropoietin produced?
By cells in the kidneys
What are the stages of RBC development?
- Rubriblasts
- Pro-rubriblasts
- Rubricytes
- Metarubricytes
- Reticulocytes
What is the function of thrombopoietin?
Stimulates the production of platelets
List the progenitor cells in thrombopoiesis.
- Megakaryoblast
- Promegakaryocyte
- Megakaryocyte
What are the stages of granulopoiesis?
- Myeloblasts
- Promyelocytes
- Myelocytes
- Band cells
- Segmented granulocytes
(Neutrophil production)
What are monoblasts?
Precursor cells similar to myeloblasts with an irregular-shaped nucleus
What is lymphopoiesis?
Production of lymphocytes
List the types of lymphocytes produced during lymphopoiesis.
- T-lymphocytes
- B-lymphocytes
- Natural killer cells (NK)
What does the suffix ‘-penia’ indicate?
Decreased number of cells